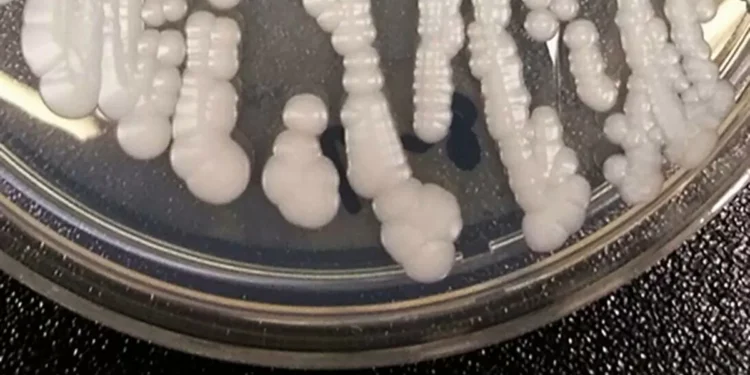
Deadly, drug-resistant fungus CDC calls ‘urgent threat’ is spreading in hospitals

A Fungus That Targets the Vulnerable: A Growing Concern in Hospitals and Senior Care Facilities
In recent years, there has been a growing concern among healthcare professionals about a particular fungus that is spreading in hospitals and senior care facilities. This fungus, known as Candida auris, has been found to prey on the sick and elderly, making it a serious threat to those who are already vulnerable. With its ability to resist common antifungal medications, Candida auris has become a major cause for alarm in the medical community.
Candida auris is a type of yeast that was first identified in 2009 in Japan. Since then, it has rapidly spread to different parts of the world, including the United States, Canada, and several countries in Europe, Asia, and South America. What makes this fungus particularly concerning is its ability to cause severe infections in people with weakened immune systems, such as the elderly and those with underlying health conditions.
In hospitals and senior care facilities, where patients are already battling illnesses and have weakened immune systems, Candida auris can easily spread and cause serious infections. This is because the fungus can survive on surfaces for a long time and can also be transmitted through contact with contaminated objects or people. In addition, the use of invasive medical procedures and devices, such as catheters and ventilators, can also increase the risk of infection.
The symptoms of a Candida auris infection can vary depending on the affected area of the body. Infections can occur in the bloodstream, wounds, respiratory tract, and urinary tract, among others. Some common symptoms include fever, chills, and fatigue. In severe cases, the infection can lead to sepsis, a life-threatening condition that occurs when the body’s response to an infection causes damage to its own tissues and organs.
What makes Candida auris even more concerning is its resistance to commonly used antifungal medications. This means that treating infections caused by this fungus can be challenging and may require the use of more potent and expensive drugs. In addition, the longer the fungus remains in a healthcare facility, the higher the chances of it spreading and causing more infections.
To combat the spread of Candida auris, healthcare facilities have implemented strict infection control measures. These include proper hand hygiene, thorough cleaning and disinfection of surfaces, and isolation of infected patients. However, these measures can only be effective if they are consistently followed by all healthcare personnel.
In addition to healthcare facilities, senior care facilities have also taken steps to prevent the spread of Candida auris among their residents. This includes regular cleaning and disinfection of common areas and resident rooms, as well as educating staff and residents about the importance of hand hygiene and infection control.
As individuals, there are also steps we can take to protect ourselves and our loved ones from Candida auris. These include practicing good hand hygiene, avoiding unnecessary use of antibiotics, and seeking medical attention if we experience any symptoms of infection.
While Candida auris may seem like a daunting threat, it is important to remember that there are measures in place to prevent its spread and effective treatments available for those who are infected. The key is to remain vigilant and work together to keep our healthcare facilities and senior care facilities safe for those who are most vulnerable.
In conclusion, the spread of Candida auris in hospitals and senior care facilities is a growing concern that requires immediate attention. With its ability to target the sick and elderly and its resistance to common antifungal medications, this fungus poses a serious threat to the health and well-being of our most vulnerable populations. By implementing strict infection control measures and working together, we can prevent the spread of Candida auris and ensure the safety of our loved ones in healthcare and senior care facilities.